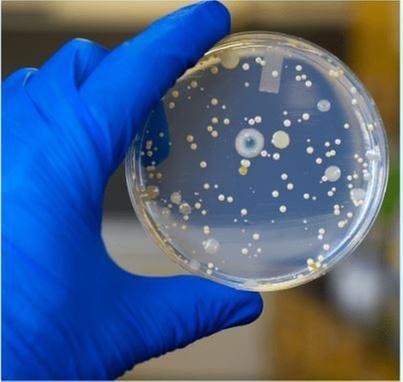
untitled

Anjali Entertainments
10100 East Fwy Ste 203
Houston, TX 77029
Anjali Entertainments is a versatile entertainment company based in Houston, TX, offering a range of services to cater to various event needs. Specializing in event planning and coordination, the company works closely with clients to create memorable experiences.
From private parties to corporate events, Anjali Entertainments provides entertainment solutions that are tailored to meet the unique requirements of each occasion. With a focus on quality and customer satisfaction, the company strives to bring creativity and professionalism to every event they are involved in.
Generated from their business information
Also at this address
See a problem?
You might also like
Partial Data by Infogroup (c) 2024. All rights reserved.